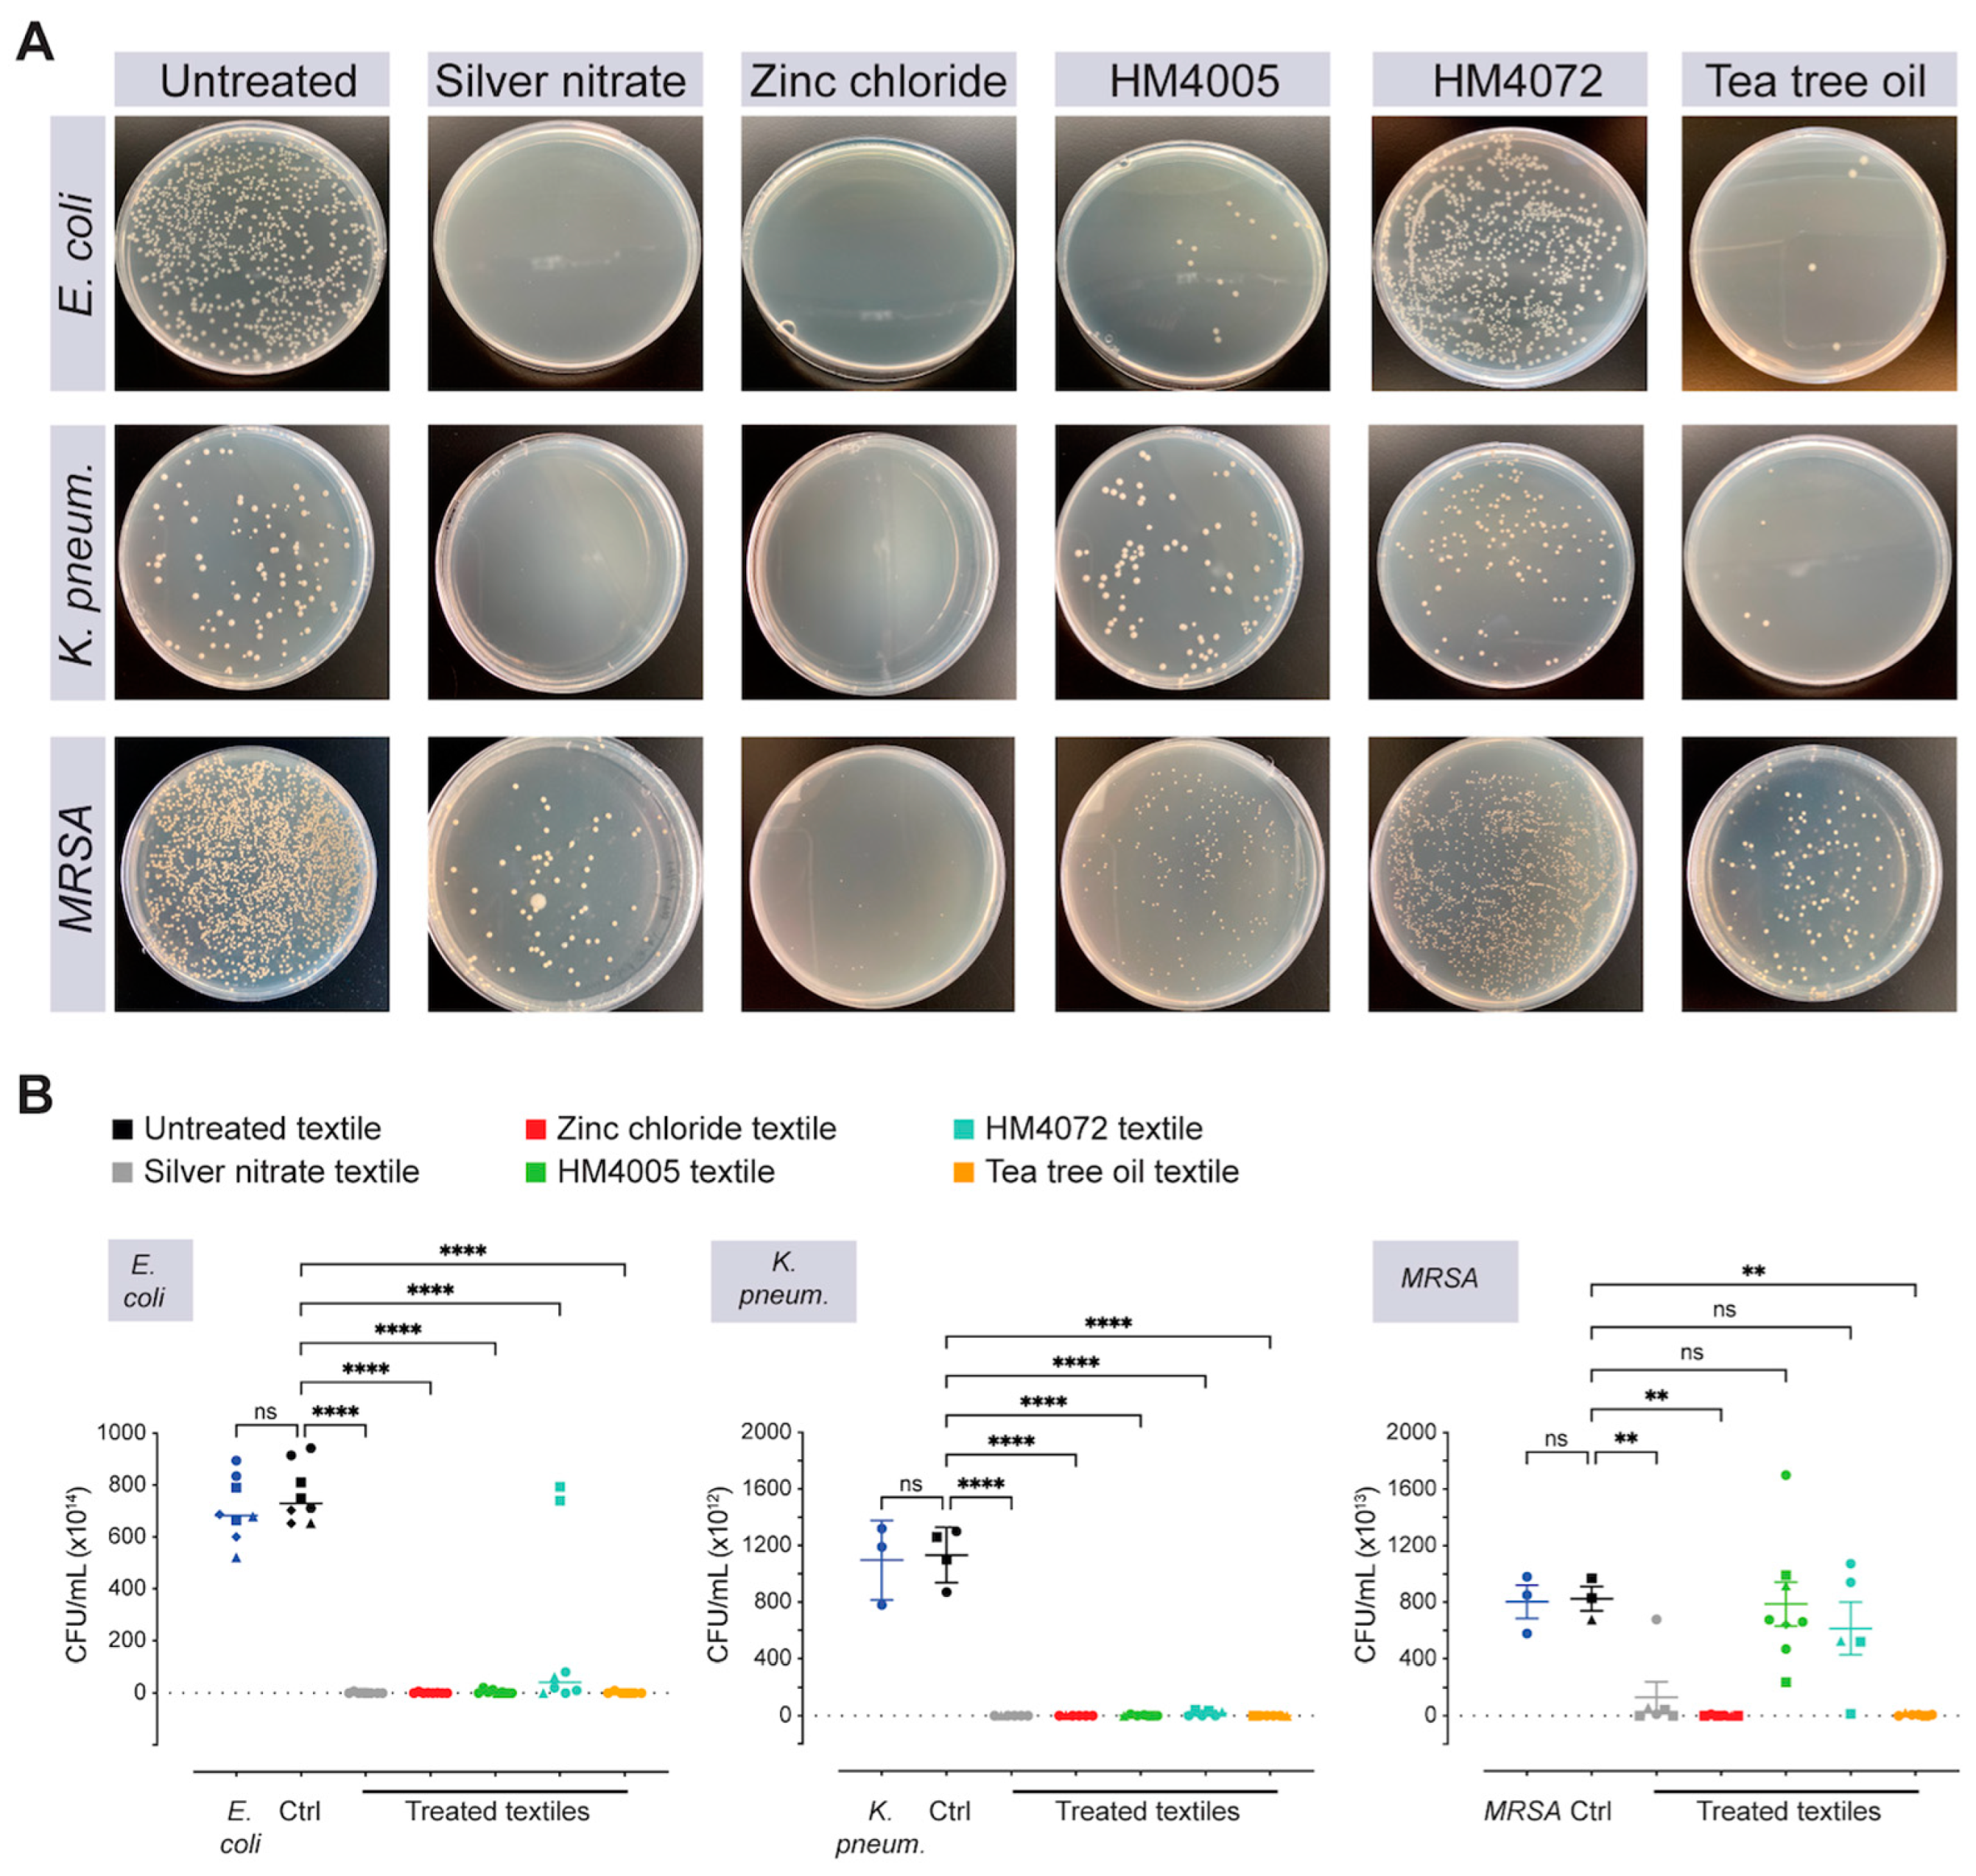
Materials 17 00383 g004a
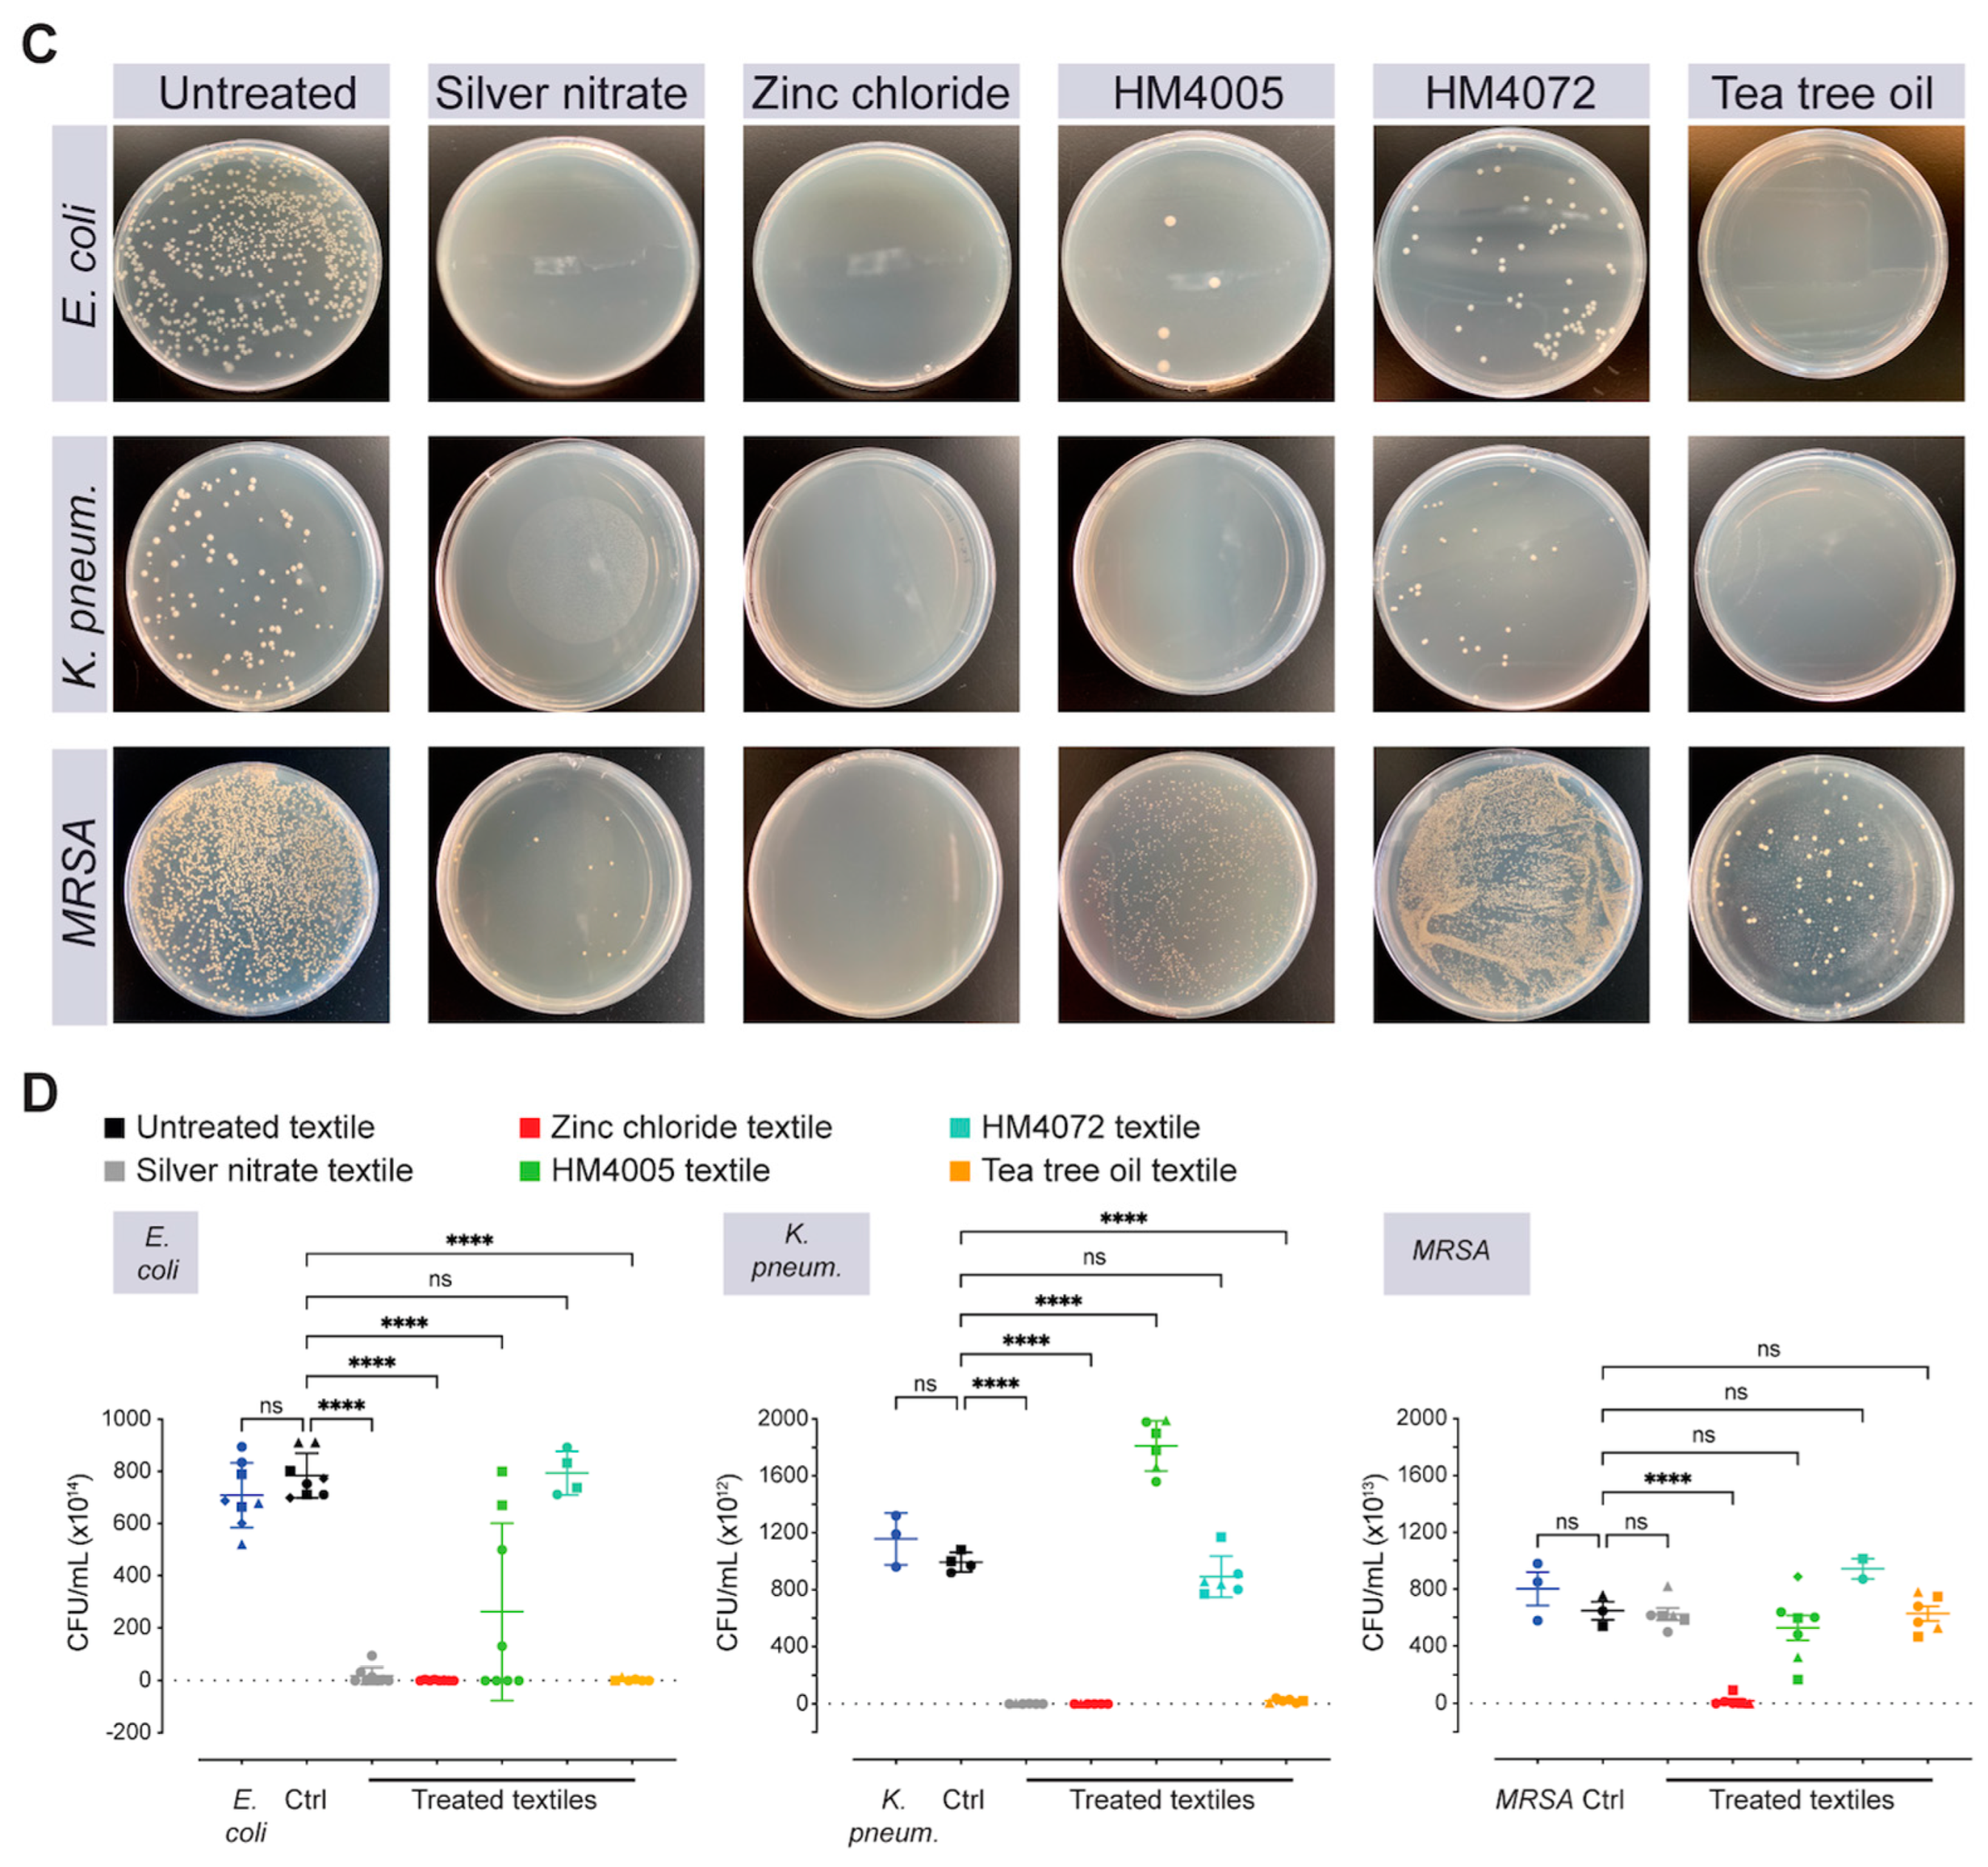
Materials 17 00383 g004b

Advancing Antimicrobial Textiles: A Comprehensive Study on Combating ESKAPE Pathogens and Ensuring User Safety
Abstract
1. Introduction
2. Materials and Methods
2.1. Materials
2.2. Preparation of Antimicrobial Textiles
2.3. Antibacterial Assessment on Coated Textiles
2.4. Textiles Leachate Preparation
2.5. Cell Culture and Cytotoxicity Assessment
2.6. Statistical Analysis
2.7. Multicriteria Decision-Making (MCDM) Analysis
- I.
- The MOORA ratio system applies the vector normalization according to Equation (2):
- II.
- The MOORA reference point approach is based on the MOORA ratio system. Following the values obtained from Equation (3), the coordinates for criteria are calculated based on Equations (4) and (5) for beneficial and non-beneficial criteria, respectively. Then, based on the deviation for the reference point and the min–max metric, the final rankings are obtained using Equation (6):
- III.
- In the MOORA full multiplicative form method, the overall utilities of the alternatives are obtained using Equation (7), which includes the maximization as well as the minimization of beneficial and non-beneficial objectives, respectively:
3. Results
3.1. Assessment of Efficacy of Antimicrobial-Functionalized Textiles in Controlled Environments
3.2. Impact of Heat Sterilization on the Durability of Antimicrobial-Coated Textiles
3.3. Assessment of the Cytotoxicity of Leachates from Antimicrobial-Functionalized Textiles on Human Dermal Fibroblasts
3.4. Optimal Antimicrobial Textile Selection Using Multicriteria Decision-Making Methods
4. Discussion
5. Conclusions
Author Contributions
Funding
Institutional Review Board Statement
Informed Consent Statement
Data Availability Statement
Acknowledgments
Conflicts of Interest
References
- Santajit, S.; Indrawattana, N. Mechanisms of Antimicrobial Resistance in ESKAPE Pathogens. Biomed. Res. Int. 2016, 2016, 2475067. [Google Scholar] [CrossRef] [PubMed]
- WHO. WHO Publishes List of Bacteria for Which New Antibiotics Are Urgently Needed. Available online: https://www.who.int/news/item/27-02-2017-who-publishes-list-of-bacteria-for-which-new-antibiotics-are-urgently-needed (accessed on 21 November 2022).
- Owen, L.; Laird, K. The role of textiles as fomites in the healthcare environment: A review of the infection control risk. PeerJ 2020, 8, e9790. [Google Scholar] [CrossRef] [PubMed]
- Kanamori, H.; Rutala, W.A.; Weber, D.J. The Role of Patient Care Items as a Fomite in Healthcare-Associated Outbreaks and Infection Prevention. Clin. Infect. Dis. 2017, 65, 1412–1419. [Google Scholar] [CrossRef] [PubMed]
- De Oliveira, D.M.P.; Forde, B.M.; Kidd, T.J.; Harris, P.N.A.; Schembri, M.A.; Beatson, S.A.; Paterson, D.L.; Walker, M.J. Antimicrobial Resistance in ESKAPE Pathogens. Clin. Microbiol. Rev. 2020, 33, e00181-19. [Google Scholar] [CrossRef]
- Patil, A.; Banerji, R.; Kanojiya, P.; Koratkar, S.; Saroj, S. Bacteriophages for ESKAPE: Role in pathogenicity and measures of control. Expert. Rev. Anti Infect. Ther. 2021, 19, 845–865. [Google Scholar] [CrossRef]
- Nielsen, J.E.; Alford, M.A.; Yung, D.B.Y.; Molchanova, N.; Fortkort, J.A.; Lin, J.S.; Diamond, G.; Hancock, R.E.W.; Jenssen, H.; Pletzer, D.; et al. Self-Assembly of Antimicrobial Peptoids Impacts Their Biological Effects on ESKAPE Bacterial Pathogens. ACS Infect. Dis. 2022, 8, 533–545. [Google Scholar] [CrossRef]
- Nakonieczna, J.; Wozniak, A.; Pieranski, M.; Rapacka-Zdonczyk, A.; Ogonowska, P.; Grinholc, M. Photoinactivation of ESKAPE pathogens: Overview of novel therapeutic strategy. Future Med. Chem. 2019, 11, 443–461. [Google Scholar] [CrossRef]
- Motiwala, T.; Mthethwa, Q.; Achilonu, I.; Khoza, T. ESKAPE Pathogens: Looking at Clp ATPases as Potential Drug Targets. Antibiotics 2022, 11, 1218. [Google Scholar] [CrossRef]
- Mulani, M.S.; Kamble, E.E.; Kumkar, S.N.; Tawre, M.S.; Pardesi, K.R. Emerging Strategies to Combat ESKAPE Pathogens in the Era of Antimicrobial Resistance: A Review. Front. Microbiol. 2019, 10, 539. [Google Scholar] [CrossRef]
- Naghavi, M.; Murray, C.J.L.; Ikuta, K.S.; Mestrovic, T.; Swetschinski, L.; Sartorius, B. Global burden of antimicrobial resistance: Essential pieces of a global puzzle—Authors’ reply. Lancet 2022, 399, 2349–2350. [Google Scholar] [CrossRef]
- Jiang, L.; Lin, J.; Taggart, C.C.; Bengoechea, J.A.; Scott, C.J. Nanodelivery strategies for the treatment of multidrug-resistant bacterial infections. J. Interdiscip. Nanomed. 2018, 3, 111–121. [Google Scholar] [CrossRef] [PubMed]
- Khameneh, B.; Eskin, N.A.M.; Iranshahy, M.; Fazly Bazzaz, B.S. Phytochemicals: A Promising Weapon in the Arsenal against Antibiotic-Resistant Bacteria. Antibiotics 2021, 10, 1044. [Google Scholar] [CrossRef] [PubMed]
- Miguel Sábio, R.; Corrêa Carvalho, G.; Li, A.J.; Chorilli, M.; Santos, H.A. Advanced porous materials for antimicrobial treatment. Nano Select. 2023. [Google Scholar] [CrossRef]
- Darpentigny, C.; Marcoux, P.R.; Menneteau, M.; Michel, B.; Ricoul, F.; Jean, B.; Bras, J.; Nonglaton, G. Antimicrobial Cellulose Nanofibril Porous Materials Obtained by Supercritical Impregnation of Thymol. ACS Appl. Bio Mater. 2020, 3, 2965–2975. [Google Scholar] [CrossRef]
- Iskandar, K.; Pecastaings, S.; LeGac, C.; Salvatico, S.; Feuillolay, C.; Guittard, M.; Marchin, L.; Verelst, M.; Roques, C. Demonstrating the In Vitro and In Situ Antimicrobial Activity of Oxide Mineral Microspheres: An Innovative Technology to Be Incorporated into Porous and Nonporous Materials. Pharmaceutics 2023, 15, 1261. [Google Scholar] [CrossRef]
- Song, K.; Wu, Q.; Zhang, Z.; Ren, S.; Lei, T.; Negulescu, I.I.; Zhang, Q. Porous Carbon Nanofibers from Electrospun Biomass Tar/Polyacrylonitrile/Silver Hybrids as Antimicrobial Materials. ACS Appl. Mater. Interfaces 2015, 7, 15108–15116. [Google Scholar] [CrossRef]
- Rosli, N.A.; Teow, Y.H.; Mahmoudi, E. Current approaches for the exploration of antimicrobial activities of nanoparticles. Sci. Technol. Adv. Mater. 2021, 22, 885–907. [Google Scholar] [CrossRef]
- Sharmin, S.; Rahaman, M.M.; Sarkar, C.; Atolani, O.; Islam, M.T.; Adeyemi, O.S. Nanoparticles as antimicrobial and antiviral agents: A literature-based perspective study. Heliyon 2021, 7, e06456. [Google Scholar] [CrossRef]
- Ramasamy, M.; Lee, J. Recent Nanotechnology Approaches for Prevention and Treatment of Biofilm-Associated Infections on Medical Devices. Biomed. Res. Int. 2016, 2016, 1851242. [Google Scholar] [CrossRef]
- Wang, L.; Hu, C.; Shao, L. The antimicrobial activity of nanoparticles: Present situation and prospects for the future. Int. J. Nanomed. 2017, 12, 1227–1249. [Google Scholar] [CrossRef]
- Yi, G.; Riduan, S.N.; Armugam, A.; Ong, J.T.; Hon, P.Y.; Abdad, M.Y.; Vasoo, S.; Ang, B.S.; Zhang, Y. Nanostructured Copper Surface Kills ESKAPE Pathogens and Viruses in Minutes. ChemMedChem 2021, 16, 3553–3558. [Google Scholar] [CrossRef]
- Wang, Y.; Wei, T.; Qu, Y.; Zhou, Y.; Zheng, Y.; Huang, C.; Zhang, Y.; Yu, Q.; Chen, H. Smart, Photothermally Activated, Antibacterial Surfaces with Thermally Triggered Bacteria-Releasing Properties. ACS Appl. Mater. Interfaces 2020, 12, 21283–21291. [Google Scholar] [CrossRef] [PubMed]
- Baumler, W.; Eckl, D.; Holzmann, T.; Schneider-Brachert, W. Antimicrobial coatings for environmental surfaces in hospitals: A potential new pillar for prevention strategies in hygiene. Crit. Rev. Microbiol. 2022, 48, 531–564. [Google Scholar] [CrossRef] [PubMed]
- Sanders, D.; Grunden, A.; Dunn, R.R. A review of clothing microbiology: The history of clothing and the role of microbes in textiles. Biol. Lett. 2021, 17, 20200700. [Google Scholar] [CrossRef] [PubMed]
- Morais, D.S.; Guedes, R.M.; Lopes, M.A. Antimicrobial Approaches for Textiles: From Research to Market. Materials 2016, 9, 498. [Google Scholar] [CrossRef]
- Insights, F.B. Antimicrobial Textiles Market, 2021–2028. 2020. Available online: https://www.fortunebusinessinsights.com/antimicrobial-textiles-market-102307 (accessed on 21 November 2023).
- Gulati, R.; Sharma, S.; Sharma, R.K. Antimicrobial textile: Recent developments and functional perspective. Polym. Bull. 2022, 79, 5747–5771. [Google Scholar] [CrossRef]
- Roman, L.E.; Gomez, E.D.; Solis, J.L.; Gomez, M.M. Antibacterial Cotton Fabric Functionalized with Copper Oxide Nanoparticles. Molecules 2020, 25, 5802. [Google Scholar] [CrossRef]
- Mehravani, B.; Ribeiro, A.I.; Zille, A. Gold Nanoparticles Synthesis and Antimicrobial Effect on Fibrous Materials. Nanomaterials 2021, 11, 1067. [Google Scholar] [CrossRef]
- Maillard, J.Y.; Hartemann, P. Silver as an antimicrobial: Facts and gaps in knowledge. Crit. Rev. Microbiol. 2013, 39, 373–383. [Google Scholar] [CrossRef]
- He, Q.; Lu, J.; Liu, N.; Lu, W.; Li, Y.; Shang, C.; Li, X.; Hu, L.; Jiang, G. Antiviral Properties of Silver Nanoparticles against SARS-CoV-2: Effects of Surface Coating and Particle Size. Nanomaterials 2022, 12, 990. [Google Scholar] [CrossRef]
- Bondarenko, O.; Juganson, K.; Ivask, A.; Kasemets, K.; Mortimer, M.; Kahru, A. Toxicity of Ag, CuO and ZnO nanoparticles to selected environmentally relevant test organisms and mammalian cells in vitro: A critical review. Arch. Toxicol. 2013, 87, 1181–1200. [Google Scholar] [CrossRef] [PubMed]
- Voelker, D.; Schlich, K.; Hohndorf, L.; Koch, W.; Kuehnen, U.; Polleichtner, C.; Kussatz, C.; Hund-Rinke, K. Approach on environmental risk assessment of nanosilver released from textiles. Environ. Res. 2015, 140, 661–672. [Google Scholar] [CrossRef] [PubMed]
- Jiao, Y.; Niu, L.N.; Ma, S.; Li, J.; Tay, F.R.; Chen, J.H. Quaternary ammonium-based biomedical materials: State-of-the-art, toxicological aspects and antimicrobial resistance. Prog. Polym. Sci. 2017, 71, 53–90. [Google Scholar] [CrossRef] [PubMed]
- Hegstad, K.; Langsrud, S.; Lunestad, B.T.; Scheie, A.A.; Sunde, M.; Yazdankhah, S.P. Does the wide use of quaternary ammonium compounds enhance the selection and spread of antimicrobial resistance and thus threaten our health? Microb. Drug Resist. 2010, 16, 91–104. [Google Scholar] [CrossRef] [PubMed]
- Jennings, M.C.; Minbiole, K.P.; Wuest, W.M. Quaternary Ammonium Compounds: An Antimicrobial Mainstay and Platform for Innovation to Address Bacterial Resistance. ACS Infect. Dis. 2015, 1, 288–303. [Google Scholar] [CrossRef]
- Stan, M.S.; Chirila, L.; Popescu, A.; Radulescu, D.M.; Radulescu, D.E.; Dinischiotu, A. Essential Oil Microcapsules Immobilized on Textiles and Certain Induced Effects. Materials 2019, 12, 2029. [Google Scholar] [CrossRef] [PubMed]
- El-Tarabily, K.A.; El-Saadony, M.T.; Alagawany, M.; Arif, M.; Batiha, G.E.; Khafaga, A.F.; Elwan, H.A.M.; Elnesr, S.S.; El-Hack, M.E.A. Using essential oils to overcome bacterial biofilm formation and their antimicrobial resistance. Saudi J. Biol. Sci. 2021, 28, 5145–5156. [Google Scholar] [CrossRef] [PubMed]
- Broadhead, R.; Craeye, L.; Callewaert, C. The Future of Functional Clothing for an Improved Skin and Textile Microbiome Relationship. Microorganisms 2021, 9, 1192. [Google Scholar] [CrossRef]
- Soroh, A.; Owen, L.; Rahim, N.; Masania, J.; Abioye, A.; Qutachi, O.; Goodyer, L.; Shen, J.; Laird, K. Microemulsification of essential oils for the development of antimicrobial and mosquito repellent functional coatings for textiles. J. Appl. Microbiol. 2021, 131, 2808–2820. [Google Scholar] [CrossRef]
- Hafezalkotob, A.; Hafezalkotob, A.; Liao, H.; Herrera, F. Interval MULTIMOORA Method Integrating Interval Borda Rule and Interval Best-Worst-Method-Based Weighting Model: Case Study on Hybrid Vehicle Engine Selection. IEEE Trans. Cybern. 2020, 50, 1157–1169. [Google Scholar] [CrossRef]
- Hafezalkotob, A.; Hafezalkotob, A.; Liao, H.; Herrera, F. An overview of MULTIMOORA for multi-criteria decision-making: Theory, developments, applications, and challenges. Inf. Fusion 2019, 51, 145–177. [Google Scholar] [CrossRef]
- Brauers, W.K.M.; Zavadskas, E.K. Project management by multimoora as an instrument for transition economies. Technol. Econ. Dev. Econ. 2010, 16, 5–24. [Google Scholar] [CrossRef]
- Brauers, W.K.M.; Zavadskas, E.K. Multimoora Optimization Used to Decide on a Bank Loan to Buy Property. Technol. Econ. Dev. Econ. 2011, 17, 174–188. [Google Scholar] [CrossRef]
- Stankevičienė, J.; Sviderskė, T.; Miečinskienė, A. Relationship between Economic Security and Country Risk Indicators in EU Baltic Sea Region Countries. Entrep. Bus. Econ. Rev. 2013, 1, 21–33. [Google Scholar] [CrossRef]
- Streimikiene, D.; Balezentis, T. Multi-objective ranking of climate change mitigation policies and measures in Lithuania. Renew. Sustain. Energy Rev. 2013, 18, 144–153. [Google Scholar] [CrossRef]
- Eghbali-Zarch, M.; Tavakkoli-Moghaddam, R.; Esfahanian, F.; Sepehri, M.M.; Azaron, A. Pharmacological therapy selection of type 2 diabetes based on the SWARA and modified MULTIMOORA methods under a fuzzy environment. Artif. Intell Med. 2018, 87, 20–33. [Google Scholar] [CrossRef]
- Liu, H.-C.; You, J.-X.; Lu, C.; Chen, Y.-Z. Evaluating health-care waste treatment technologies using a hybrid multi-criteria decision making model. Renew. Sustain. Energy Rev. 2015, 41, 932–942. [Google Scholar] [CrossRef]
- Brauers, W.K.M.; Zavadskas, E.K. Robustness of MULTIMOORA: A Method for Multi-Objective Optimization. Informatica 2012, 23, 1–25. [Google Scholar] [CrossRef]
- Novi, V.T.; Gonzalez, A.; Brockgreitens, J.; Abbas, A. Highly efficient and durable antimicrobial nanocomposite textiles. Sci. Rep. 2022, 12, 17332. [Google Scholar] [CrossRef]
- Schneider, G.; Bim, F.L.; Sousa, A.F.L.; Watanabe, E.; Andrade, D.; Fronteira, I. The use of antimicrobial-impregnated fabrics in health services: An integrative review. Rev. Lat. Am. Enfermagem. 2021, 29, e3416. [Google Scholar] [CrossRef]
- European Commission, The Community and Development Information Service (CORDIS). Reducing Hospital Infections through Innovative Textiles. Available online: https://cordis.europa.eu/article/id/91169-reducing-hospital-infections-through-innovative-textiles (accessed on 21 November 2022).
- Aswathy, B.; Avadhani, G.S.; Sumithra, S.; Suji, S.; Sony, G. Microwave assisted synthesis and UV–Vis spectroscopic studies of silver nanoparticles synthesized using vanillin as a reducing agent. J. Mol. Liq. 2011, 159, 165–169. [Google Scholar] [CrossRef]
- Alia, S.W.; Rajendranb, S.; Joshi, M. Synthesis and characterization of chitosan and silver loaded chitosan nanoparticles for bioactive polyester. Carbohydr. Polym. 2011, 83, 438–446. [Google Scholar] [CrossRef]
- Dias, H.B.; Bernardi, M.I.B.; Marangoni, V.S.; de Abreu Bernardi, A.C.; de Souza Rastelli, A.N.; Hernandes, A.C. Synthesis, characterization and application of Ag doped ZnO nanoparticles in a composite resin. Mater. Sci. Eng. C Mater. Biol. Appl. 2019, 96, 391–401. [Google Scholar] [CrossRef] [PubMed]
- Xu, Q.; Wu, Y.; Zhang, Y.; Fu, F.; Liu, X. Durable Antibacterial Cotton Modified by Silver Nanoparticles and Chitosan Derivative Binder. Fibers Polym. 2016, 17, 1782–1789. [Google Scholar] [CrossRef]
- Saravanan, M.; Barik, S.K.; MubarakAli, D.; Prakash, P.; Pugazhendhi, A. Synthesis of silver nanoparticles from Bacillus brevis (NCIM 2533) and their antibacterial activity against pathogenic bacteria. Microb. Pathog. 2018, 116, 221–226. [Google Scholar] [CrossRef]
- Hiragonda, C.B.; Kshirsagara, A.S.; Dhapteb, V.V.; Khannaa, T.; Joshia, P.; More, P.V. Enhanced anti-microbial response of commercial face mask using colloidal T silver nanoparticles. Vacuum 2018, 156, 475–482. [Google Scholar] [CrossRef]
- Holt, B.A.; Gregory, S.A.; Sulchek, T.; Yee, S.; Losego, M.D. Aqueous Zinc Compounds as Residual Antimicrobial Agents for Textiles. ACS Appl. Mater. Interfaces 2018, 10, 7709–7716. [Google Scholar] [CrossRef]
- El-Shishtawy, R.M.; Asiri, A.M.; Abdelwahed, N.A.M.; Al-Otaibi, M.M. In situ production of silver nanoparticle on cotton fabric and its antimicrobial evaluation. Cellulose 2011, 18, 75–82. [Google Scholar] [CrossRef]
- Xua, Q.; Xiea, L.; Diaob, H.; Lia, F.; Zhanga, Y.; Fua, F.; Liu, X. Antibacterial cotton fabric with enhanced durability prepared using silver nanoparticles and carboxymethyl chitosan. Carbohydr. Polym. 2017, 177, 187–193. [Google Scholar] [CrossRef]
- Irfan, M.; Hussain, H.; Saleem, B.; Saleem, M.; Shukrullah, S.; Legutko, S.; Petru, J.; Naz, M.Y.; Pagac, M.; Rahman, S.; et al. Evaluation of Ultrasonically ZnO Loading Effect on Photocatalytic Self-Cleaning, UV Protection and Antibacterial Activity of Plasma/Citric Acid-Activated Cotton Fabric. Nanomaterials 2022, 12, 2122. [Google Scholar] [CrossRef]
- Jain, A.; Kongkham, B.; Puttaswamy, H.; Butola, B.S.; Malik, H.K.; Malik, A. Development of Wash-Durable Antimicrobial Cotton Fabrics by In Situ Green Synthesis of Silver Nanoparticles and Investigation of Their Antimicrobial Efficacy against Drug-Resistant Bacteria. Antibiotics 2022, 11, 864. [Google Scholar] [CrossRef] [PubMed]
- Liao, C.; Li, Y.; Tjong, S.C. Bactericidal and Cytotoxic Properties of Silver Nanoparticles. Int. J. Mol. Sci. 2019, 20, 449. [Google Scholar] [CrossRef]
- Bayer, A.S.; Kupferwasser, L.I.; Brown, M.H.; Skurray, R.A.; Grkovic, S.; Jones, T.; Mukhopadhay, K.; Yeaman, M.R. Low-level resistance of Staphylococcus aureus to thrombin-induced platelet microbicidal protein 1 in vitro associated with qacA gene carriage is independent of multidrug efflux pump activity. Antimicrob. Agents Chemother. 2006, 50, 2448–2454. [Google Scholar] [CrossRef] [PubMed]
- Brown, M.H.; Skurray, R.A. Staphylococcal multidrug efflux protein QacA. J. Mol. Microbiol. Biotechnol. 2001, 3, 163–170. [Google Scholar]
- Paulsen, I.T.; Brown, M.H.; Littlejohn, T.G.; Mitchell, B.A.; Skurray, R.A. Multidrug resistance proteins QacA and QacB from Staphylococcus aureus: Membrane topology and identification of residues involved in substrate specificity. Proc. Natl. Acad. Sci. USA 1996, 93, 3630–3635. [Google Scholar] [CrossRef]
- Jennings, M.C.; Forman, M.E.; Duggan, S.M.; Minbiole, K.P.C.; Wuest, W.M. Efflux Pumps Might Not Be the Major Drivers of QAC Resistance in Methicillin-Resistant Staphylococcus aureus. Chembiochem 2017, 18, 1573–1577. [Google Scholar] [CrossRef]
- Mahoney, A.R.; Safaee, M.M.; Wuest, W.M.; Furst, A.L. The silent pandemic: Emergent antibiotic resistances following the global response to SARS-CoV-2. iScience 2021, 24, 102304. [Google Scholar] [CrossRef] [PubMed]
- Rovira, J.; Domingo, J.L. Human health risks due to exposure to inorganic and organic chemicals from textiles: A review. Environ. Res. 2019, 168, 62–69. [Google Scholar] [CrossRef]
- Iadaresta, F.; Manniello, M.D.; Ostman, C.; Crescenzi, C.; Holmback, J.; Russo, P. Chemicals from textiles to skin: An in vitro permeation study of benzothiazole. Environ. Sci. Pollut. Res. Int. 2018, 25, 24629–24638. [Google Scholar] [CrossRef]
- Stefaniak, A.B.; Duling, M.G.; Lawrence, R.B.; Thomas, T.A.; LeBouf, R.F.; Wade, E.E.; Virji, M.A. Dermal exposure potential from textiles that contain silver nanoparticles. Int. J. Occup. Environ. Health 2014, 20, 220–234. [Google Scholar] [CrossRef]
- Sahu, S.C.; Zheng, J.; Graham, L.; Chen, L.; Ihrie, J.; Yourick, J.J.; Sprando, R.L. Comparative cytotoxicity of nanosilver in human liver HepG2 and colon Caco2 cells in culture. J. Appl. Toxicol. 2014, 34, 1155–1166. [Google Scholar] [CrossRef]
- Shi, J.; Sun, X.; Lin, Y.; Zou, X.; Li, Z.; Liao, Y.; Du, M.; Zhang, H. Endothelial cell injury and dysfunction induced by silver nanoparticles through oxidative stress via IKK/NF-kappaB pathways. Biomaterials 2014, 35, 6657–6666. [Google Scholar] [CrossRef]
- Sabella, S.; Carney, R.P.; Brunetti, V.; Malvindi, M.A.; Al-Juffali, N.; Vecchio, G.; Janes, S.M.; Bakr, O.M.; Cingolani, R.; Stellacci, F.; et al. A general mechanism for intracellular toxicity of metal-containing nanoparticles. Nanoscale 2014, 6, 7052–7061. [Google Scholar] [CrossRef]
- Carrola, J.; Bastos, V.; Jarak, I.; Oliveira-Silva, R.; Malheiro, E.; Daniel-da-Silva, A.L.; Oliveira, H.; Santos, C.; Gil, A.M.; Duarte, I.F. Metabolomics of silver nanoparticles toxicity in HaCaT cells: Structure-activity relationships and role of ionic silver and oxidative stress. Nanotoxicology 2016, 10, 1105–1117. [Google Scholar] [CrossRef]
- Jiang, X.; Lu, C.; Tang, M.; Yang, Z.; Jia, W.; Ma, Y.; Jia, P.; Pei, D.; Wang, H. Nanotoxicity of Silver Nanoparticles on HEK293T Cells: A Combined Study Using Biomechanical and Biological Techniques. ACS Omega 2018, 3, 6770–6778. [Google Scholar] [CrossRef]
- Li, L.; Cui, J.; Liu, Z.; Zhou, X.; Li, Z.; Yu, Y.; Jia, Y.; Zuo, D.; Wu, Y. Silver nanoparticles induce SH-SY5Y cell apoptosis via endoplasmic reticulum- and mitochondrial pathways that lengthen endoplasmic reticulum-mitochondria contact sites and alter inositol-3-phosphate receptor function. Toxicol. Lett. 2018, 285, 156–167. [Google Scholar] [CrossRef] [PubMed]
- Kim, M.J.; Shin, S. Toxic effects of silver nanoparticles and nanowires on erythrocyte rheology. Food Chem. Toxicol. 2014, 67, 80–86. [Google Scholar] [CrossRef]
- Montes-Hernandez, G.; Di Girolamo, M.; Sarret, G.; Bureau, S.; Fernandez-Martinez, A.; Lelong, C.; Eymard Vernain, E. In Situ Formation of Silver Nanoparticles (Ag-NPs) onto Textile Fibers. ACS Omega 2021, 6, 1316–1327. [Google Scholar] [CrossRef] [PubMed]
- Gupta, T.; Talukder, G.; Sharma, A. Cytotoxicity of zinc chloride in mice in vivo. Biol. Trace Elem. Res. 1991, 30, 95–101. [Google Scholar] [CrossRef] [PubMed]
- Salesa, B.; Sabater, I.S.R.; Serrano-Aroca, A. Zinc Chloride: Time-Dependent Cytotoxicity, Proliferation and Promotion of Glycoprotein Synthesis and Antioxidant Gene Expression in Human Keratinocytes. Biology 2021, 10, 1072. [Google Scholar] [CrossRef]
- Cosmetic Ingredient Review (CIR). Safety Assessment of Zinc Salts as Used in Cosmetics. Available online: https://www.cir-safety.org/sites/default/files/zincst092017SLR.pdf (accessed on 21 November 2022).
- Melin, V.E.; Potineni, H.; Hunt, P.; Griswold, J.; Siems, B.; Werre, S.R.; Hrubec, T.C. Exposure to common quaternary ammonium disinfectants decreases fertility in mice. Reprod. Toxicol. 2014, 50, 163–170. [Google Scholar] [CrossRef]
- Christen, V.; Faltermann, S.; Brun, N.R.; Kunz, P.Y.; Fent, K. Cytotoxicity and molecular effects of biocidal disinfectants (quaternary ammonia, glutaraldehyde, poly(hexamethylene biguanide) hydrochloride PHMB) and their mixtures in vitro and in zebrafish eleuthero-embryos. Sci. Total Environ. 2017, 586, 1204–1218. [Google Scholar] [CrossRef]
- Hayes, A.J.; Leach, D.N.; Markham, J.L.; Markovic, B. In vitro Cytotoxicity of Australian Tea Tree Oil using Human Cell Lines. J. Essent. Oil Res. 2011, 9, 575–582. [Google Scholar] [CrossRef]
- Hammer, K.A.; Carson, C.F.; Riley, T.V.; Nielsen, J.B. A review of the toxicity of Melaleuca alternifolia (tea tree) oil. Food Chem. Toxicol. 2006, 44, 616–625. [Google Scholar] [CrossRef]
- Dahooie, J.H.; Zavadskas, E.; Firoozfar, H.; Vanaki, A.; Mohammadi, N.; Brauers, W. An improved fuzzy MULTIMOORA approach for multi-criteria decision making based on objective weighting method (CCSD) and its application to technological forecasting method selection. Eng. Appl. Artif. Intell. 2019, 79, 114–128. [Google Scholar] [CrossRef]
- Baležentis, A.; Baležentis, T.; Brauers, W.K. Personnel selection based on computing with words and fuzzy MULTIMOORA. Expert Syst. Appl. 2012, 39, 7961–7967. [Google Scholar] [CrossRef]
- Liu, H.-C.; Fan, X.-J.; Li, P.; Chen, Y.-Z. Evaluating the risk of failure modes with extended MULTIMOORA method under fuzzy environment. Eng. Appl. Artif. Intell. 2014, 34, 168–177. [Google Scholar] [CrossRef]
- Fedajev, A.; Stanujkic, D.; Karabašević, D.; Brauers, W.K.; Zavadskas, E.K. Assessment of progress towards “Europe 2020” strategy targets by using the MULTIMOORA method and the Shannon Entropy Index. J. Clean. Prod. 2020, 244, 118895. [Google Scholar] [CrossRef]
- Alkan, Ö.; Albayrak, K. Ranking of renewable energy sources for regions in Turkey by fuzzy entropy based fuzzy COPRAS and fuzzy MULTIMOORA. Renew. Energy 2020, 162, 712–726. [Google Scholar] [CrossRef]
- Ulutaş, A.; Stanujkic, D.; Karabasevic, D.; Popovic, G.; Zavadskas, E.K.; Smarandache, F.; Brauers, W.K. Developing of a Novel Integrated MCDM MULTIMOOSRAL Approach for Supplier Selection. Informatica 2021, 32, 145–161. [Google Scholar] [CrossRef]
- Baležentis, T.; Baležentis, A. A Survey on Development and Applications of the Multi-criteria Decision Making Method MULTIMOORA. J. Multi-Criteria Decis. Anal. 2014, 21, 209–222. [Google Scholar] [CrossRef]

| Target | Agent | IC50 | SE | dfs |
|---|---|---|---|---|
| HDFs | Silver nitrate | 0.004 mM | 0.002 | 30 |
| Zinc chloride | 1.621 mM | 0.062 | 25 | |
| HM4005 | 0.08% | 0.076 | 28 | |
| HM4072 | 0.001% | 0.001 | 28 | |
| Tea tree oil | 0.15% | 0.051 | 29 |
| Fabric Coating Agents Name | BR (%) E. coli | BR (%) K. pneum | BR (%) MRSA |
|---|---|---|---|
| Silver nitrate | 99.87 | 100 | 84.05 |
| Silver nitrate Sterilized | 97.67 | 100 | 24.35 |
| Zinc Chloride | 99.87 | 100 | 99.71 |
| Zinc Chloride Sterilized | 99.85 | 100 | 97.83 |
| HM4005 | 99.34 | 100 | 0 |
| HM4005 Sterilized | 65.78 | 0 | 36.03 |
| HM4072 | 72.18 | 98.35 | 25.52 |
| HM4072 Sterilized | 0 | 21.48 | 0 |
| Tea tree oil | 100 | 100 | 99.13 |
| Tea tree oil Sterilized | 100 | 97.67 | 23.88 |
| AM Properties (% BR) | Toxicity (% Viability) | Heat Sensitivity (Binary) | Leaching (Binary) | Easy to Use (Binary) | Price USD | Odor (Binary) | Color (Binary) | |
|---|---|---|---|---|---|---|---|---|
| BENEFIT | BENEFIT | COST | COST | BENEFIT | COST | COST | COST | |
| Silver Nitrate | 84.49 | 100 | 1 | 0 | 1 | 10.6 | 0 | 1 |
| Zinc chloride | 99.54 | 20 | 0 | 1 | 1 | 8.51 | 0 | 1 |
| HM4005 | 50.19 | 40 | 1 | 1 | 0 | 2.2 | 0 | 0 |
| HM4072 | 36.25 | 15 | 1 | 1 | 0 | 4.78 | 0 | 0 |
| Tea tree oil | 86.74 | 55 | 0 | 0 | 0 | 18.67 | 1 | 1 |
| Health Scientist/Engineer | Industry Partners | Final Weights | |||||
|---|---|---|---|---|---|---|---|
| Expert ID | 1 | 2 | 3 | 1 | 2 | 3 | |
| Expert’s Opinion Weight | 0.15 | 0.15 | 0.15 | 0.225 | 0.225 | 0.1 | 1 |
| AM properties | 0.25 | 0.3 | 0.3 | 0.3 | 0.2 | 0.2 | 0.2600 |
| Toxicity | 0.25 | 0.3 | 0.3 | 0.2 | 0.2 | 0.25 | 0.2425 |
| Heat Sensitivity | 0.1 | 0.1 | 0 | 0.05 | 0.05 | 0.1 | 0.0625 |
| Leaching | 0.15 | 0.1 | 0.1 | 0.15 | 0.05 | 0.075 | 0.1050 |
| Easy Usage | 0.05 | 0.05 | 0 | 0.07 | 0.1 | 0.15 | 0.0682 |
| Price | 0.1 | 0.05 | 0.1 | 0.05 | 0.2 | 0.075 | 0.1012 |
| Odor | 0.05 | 0.05 | 0.1 | 0.08 | 0.1 | 0.1 | 0.0805 |
| Color | 0.05 | 0.05 | 0.1 | 0.1 | 0.1 | 0.05 | 0.0800 |
| SUM | 1 | 1 | 1 | 1 | 1 | 1 | 1 |
Disclaimer/Publisher’s Note: The statements, opinions and data contained in all publications are solely those of the individual author(s) and contributor(s) and not of MDPI and/or the editor(s). MDPI and/or the editor(s) disclaim responsibility for any injury to people or property resulting from any ideas, methods, instructions or products referred to in the content. |
© 2024 by the authors. Licensee MDPI, Basel, Switzerland. This article is an open access article distributed under the terms and conditions of the Creative Commons Attribution (CC BY) license (https://creativecommons.org/licenses/by/4.0/).
Share and Cite
Vojnits, K.; Mohseni, M.; Parvinzadeh Gashti, M.; Nadaraja, A.V.; Karimianghadim, R.; Crowther, B.; Field, B.; Golovin, K.; Pakpour, S. Advancing Antimicrobial Textiles: A Comprehensive Study on Combating ESKAPE Pathogens and Ensuring User Safety. Materials 2024, 17, 383. https://doi.org/10.3390/ma17020383
Vojnits K, Mohseni M, Parvinzadeh Gashti M, Nadaraja AV, Karimianghadim R, Crowther B, Field B, Golovin K, Pakpour S. Advancing Antimicrobial Textiles: A Comprehensive Study on Combating ESKAPE Pathogens and Ensuring User Safety. Materials. 2024; 17(2):383. https://doi.org/10.3390/ma17020383
Chicago/Turabian StyleVojnits, Kinga, Majid Mohseni, Mazeyar Parvinzadeh Gashti, Anupama Vijaya Nadaraja, Ramin Karimianghadim, Ben Crowther, Brad Field, Kevin Golovin, and Sepideh Pakpour. 2024. "Advancing Antimicrobial Textiles: A Comprehensive Study on Combating ESKAPE Pathogens and Ensuring User Safety" Materials 17, no. 2: 383. https://doi.org/10.3390/ma17020383
APA StyleVojnits, K., Mohseni, M., Parvinzadeh Gashti, M., Nadaraja, A. V., Karimianghadim, R., Crowther, B., Field, B., Golovin, K., & Pakpour, S. (2024). Advancing Antimicrobial Textiles: A Comprehensive Study on Combating ESKAPE Pathogens and Ensuring User Safety. Materials, 17(2), 383. https://doi.org/10.3390/ma17020383

